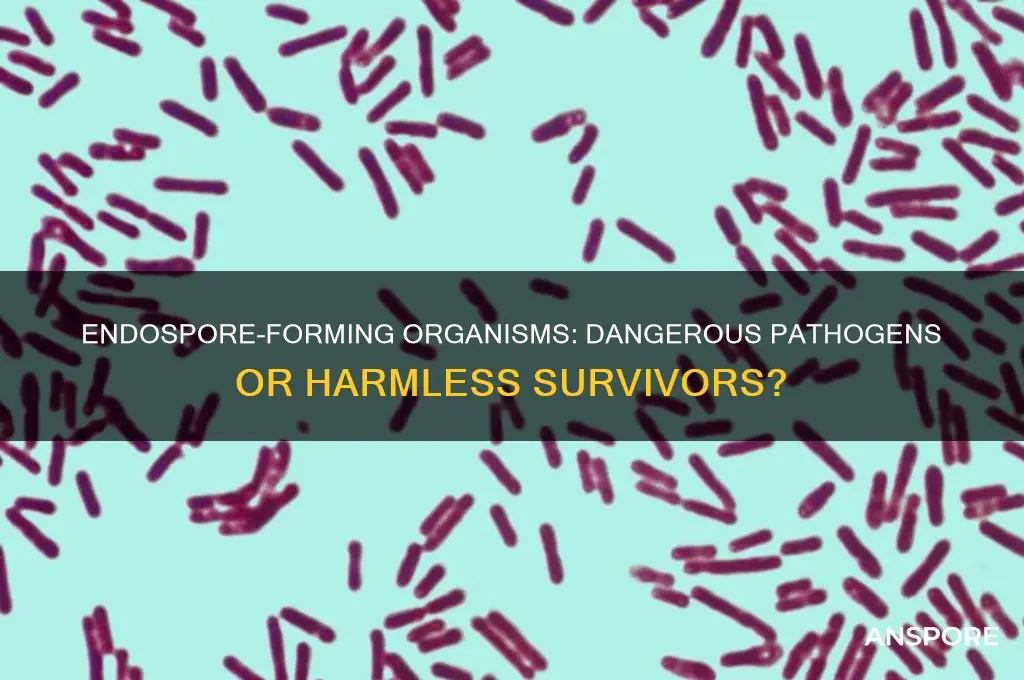
are endo spore forming organism dangerous pathogens

Endospore-forming organisms, such as certain species of *Bacillus* and *Clostridium*, are known for their ability to produce highly resistant endospores that can survive extreme conditions, including heat, radiation, and desiccation. While not all endospore-forming organisms are pathogenic, some, like *Clostridium botulinum* (causative agent of botulism) and *Bacillus anthracis* (causative agent of anthrax), are indeed dangerous pathogens. Their ability to form endospores allows them to persist in the environment for extended periods, increasing the risk of contamination and infection. However, it is important to note that the majority of endospore-forming organisms are harmless or even beneficial, playing roles in soil ecology and industrial processes. Thus, while some pose significant health risks, the danger associated with endospore-forming organisms depends largely on the specific species and context.
| Characteristics | Values |
|---|---|
| Pathogenic Potential | Some endospore-forming organisms are dangerous pathogens (e.g., Clostridium botulinum, Bacillus anthracis), while others are non-pathogenic or opportunistic (e.g., Bacillus subtilis). |
| Spores' Resistance | Endospores are highly resistant to extreme conditions (heat, radiation, desiccation, chemicals), making them difficult to eradicate. |
| Infection Mechanism | Pathogenic species can cause disease through toxin production (e.g., botulinum toxin) or direct tissue invasion (e.g., anthrax). |
| Environmental Persistence | Spores can survive in soil, water, and healthcare settings for years, increasing infection risk. |
| Treatment Challenges | Spores are resistant to many disinfectants and antibiotics, requiring specialized treatments (e.g., high-pressure steam sterilization). |
| Disease Examples | Anthrax, botulism, tetanus, gas gangrene, and food poisoning caused by Clostridium perfringens. |
| Public Health Concern | Considered significant threats due to their resilience, potential for bioterrorism, and difficulty in detection and control. |
| Non-Pathogenic Species | Many endospore-forming bacteria (e.g., Bacillus cereus) are harmless or beneficial in industrial applications. |
| Sporulation Trigger | Spores form in response to nutrient depletion or environmental stress, not inherently linked to pathogenicity. |
| Detection Methods | Advanced techniques like PCR, spore staining, and culture-based methods are used to identify pathogenic species. |
Explore related products
What You'll Learn
- Endospore Resistance Mechanisms: How endospores survive extreme conditions like heat, radiation, and chemicals
- Pathogenicity of Endospore Formers: Which endospore-forming bacteria cause diseases in humans and animals
- Food Contamination Risks: Role of endospores in foodborne illnesses and spoilage
- Medical Treatment Challenges: Difficulty in treating infections caused by endospore-forming pathogens
- Environmental Persistence: How endospores remain dormant and spread in various environments

Endospore Resistance Mechanisms: How endospores survive extreme conditions like heat, radiation, and chemicals
Endospores, the dormant form of certain bacteria, are nature's ultimate survivalists. They can withstand conditions that would destroy most life forms, including extreme heat, radiation, and harsh chemicals. This resilience makes them a fascinating subject of study and a significant concern in fields like food safety, healthcare, and environmental science. But how do they achieve such remarkable resistance?
The Structure of Survival
At the heart of endospore resistance is their unique structure. Unlike vegetative bacterial cells, endospores have multiple protective layers, including a thick spore coat composed of keratin-like proteins and a cortex rich in peptidoglycan. These layers act as a barrier, shielding the spore's genetic material and enzymes from external threats. Additionally, the core of the endospore contains high levels of calcium dipicolinate, a compound that binds water molecules, reducing the core's hydration and slowing metabolic activity to nearly zero. This near-complete shutdown of cellular processes minimizes damage from stressors like heat and radiation.
Heat Resistance: A Molecular Shield
One of the most striking features of endospores is their ability to survive temperatures that would denature proteins and destroy DNA in other organisms. For example, *Clostridium botulinum* endospores can survive boiling water (100°C) for several hours. This resistance is partly due to the spore coat's low water content and the stabilization of proteins by calcium dipicolinate. To kill endospores, temperatures exceeding 121°C are required, typically achieved through autoclaving for 15–30 minutes. This is why sterilization protocols in laboratories and food processing industries are designed to target these resilient structures.
Radiation and Chemical Resistance: A Double Defense
Endospores also resist ionizing radiation and chemicals like hydrogen peroxide and ethanol, which are lethal to most cells. Their resistance to radiation stems from their DNA's compact and protected state, as well as efficient DNA repair mechanisms activated upon germination. Against chemicals, the spore coat acts as a physical barrier, slowing the penetration of toxic substances. For instance, while 70% ethanol is effective against vegetative bacteria, it has little effect on endospores. Decontamination requires stronger agents like bleach (5% sodium hypochlorite) or prolonged exposure to high concentrations of disinfectants.
Practical Implications and Mitigation Strategies
Understanding endospore resistance is crucial for managing their risks. In healthcare, endospores of *Clostridioides difficile* can survive on surfaces for months, contributing to hospital-acquired infections. Regular cleaning with spore-specific disinfectants and proper hand hygiene are essential. In food processing, endospores of *Bacillus cereus* and *Clostridium perfringens* can survive cooking, causing foodborne illnesses if not eliminated through proper canning or pasteurization techniques. For individuals, ensuring food is heated to safe temperatures (above 74°C for at least 10 minutes) and storing perishables correctly can reduce risks.
In summary, endospore resistance mechanisms are a marvel of evolutionary adaptation, but they also pose practical challenges. By understanding how these structures survive extreme conditions, we can develop more effective strategies to control and eliminate them, safeguarding health and safety in various contexts.
Are Black Mold Spores Airborne? Understanding the Risks and Spread
You may want to see also

Pathogenicity of Endospore Formers: Which endospore-forming bacteria cause diseases in humans and animals
Endospore-forming bacteria are renowned for their remarkable resilience, capable of surviving extreme conditions such as heat, radiation, and desiccation. While many are harmless or even beneficial, certain species pose significant health risks to humans and animals. Among the most notorious pathogenic endospore formers are *Clostridium* and *Bacillus* species, which can cause a range of diseases from mild infections to life-threatening conditions. Understanding their pathogenicity is crucial for prevention, diagnosis, and treatment.
Consider *Clostridium difficile*, a leading cause of antibiotic-associated diarrhea and colitis, particularly in hospitalized patients over 65 years old. This bacterium produces spores that persist in healthcare environments, making it a persistent threat. Infection often occurs after antibiotic use disrupts the gut microbiome, allowing *C. difficile* to overgrow and release toxins. Treatment typically involves discontinuing the offending antibiotic and administering specific antibiotics like vancomycin or fidaxomicin. Preventive measures include rigorous hand hygiene, environmental disinfection, and judicious antibiotic use.
Another significant pathogen is *Bacillus anthracis*, the causative agent of anthrax. This bacterium forms spores that can remain viable in soil for decades, posing risks to livestock and humans, particularly in agricultural settings. Anthrax manifests in three forms: cutaneous, inhalation, and gastrointestinal, with inhalation anthrax being the most lethal. Early diagnosis is critical, as delayed treatment significantly increases mortality. Prophylactic antibiotics such as ciprofloxacin or doxycycline are recommended for exposed individuals, while vaccination is available for high-risk groups like veterinarians and lab workers.
In contrast to these well-known pathogens, *Clostridium botulinum* causes botulism, a rare but severe illness characterized by muscle paralysis. Spores of this bacterium can contaminate improperly canned foods or wound sites, producing potent neurotoxins. Infants under one year old are particularly vulnerable to intestinal botulism from consuming spores in honey or soil. Treatment involves antitoxin administration and supportive care, including mechanical ventilation in severe cases. Prevention focuses on proper food handling, avoiding honey for infants, and prompt wound care.
While these examples highlight the dangers of certain endospore formers, not all are harmful. For instance, *Bacillus subtilis* is widely used in probiotics and soil remediation. However, the pathogenic species underscore the importance of targeted surveillance and control measures. Healthcare providers, veterinarians, and food safety experts must remain vigilant to mitigate the risks posed by these resilient organisms. By understanding their mechanisms of infection and transmission, we can better protect human and animal health.
Understanding Spore Plants: A Beginner's Guide to Their Unique Life Cycle
You may want to see also

Food Contamination Risks: Role of endospores in foodborne illnesses and spoilage
Endospores, the dormant, highly resistant structures produced by certain bacteria, pose a significant but often overlooked threat in food safety. Unlike their vegetative counterparts, endospores can survive extreme conditions—heat, radiation, and desiccation—making them formidable contaminants in food processing environments. Their ability to persist in adverse conditions means they can remain viable for years, waiting for optimal conditions to reactivate and multiply. This resilience is particularly concerning in the context of foodborne illnesses and spoilage, where even a small number of endospores can lead to widespread contamination.
Consider the case of *Clostridium botulinum*, an endospore-forming bacterium notorious for producing botulinum toxin, one of the most potent toxins known. In low-acid, anaerobic environments like canned foods, dormant endospores can germinate, grow, and produce toxin, leading to botulism—a potentially fatal illness. Even a single cell’s worth of toxin (approximately 0.0007–0.003 micrograms) can be lethal to humans. Similarly, *Bacillus cereus*, another endospore-former, causes food poisoning through heat-resistant spores that survive cooking and germinate in cooked rice or pasta stored at room temperature, producing toxins that cause nausea, vomiting, and diarrhea.
Preventing endospore-related contamination requires a multi-faceted approach. First, thermal processing, such as autoclaving at 121°C for 15–30 minutes, effectively destroys endospores in canned foods. However, this method is not suitable for all food types, particularly heat-sensitive products. For these, alternative strategies like high-pressure processing (HPP) or irradiation can be employed, though they may alter food texture or flavor. Second, proper storage is critical. Refrigerating cooked foods below 4°C inhibits spore germination, while discarding perishable items left at room temperature for over 2 hours reduces risk. Lastly, educating food handlers about the risks of cross-contamination and the importance of hygiene is essential, as endospores can persist on surfaces and equipment.
Comparatively, while vegetative bacteria are more commonly associated with foodborne illnesses, endospores present a unique challenge due to their durability. For instance, *Salmonella* or *E. coli* are typically eliminated by thorough cooking, but endospores from *Bacillus* or *Clostridium* species may survive such treatments. This distinction underscores the need for targeted strategies to address endospore risks. Unlike general bacterial contamination, which can often be mitigated by basic sanitation, endospore control demands specific interventions, such as spore-specific sanitizers or stringent time-temperature protocols.
In conclusion, endospores are silent saboteurs in the food industry, capable of causing severe illnesses and spoilage despite their dormant state. Their resistance to conventional preservation methods necessitates a proactive, informed approach to food safety. By understanding their behavior and implementing tailored strategies, from thermal processing to proper storage, the risks posed by these resilient structures can be minimized, safeguarding public health and food quality.
Understanding Bacterial Spores: Formation, Function, and Survival Mechanisms
You may want to see also

Medical Treatment Challenges: Difficulty in treating infections caused by endospore-forming pathogens
Endospore-forming pathogens, such as *Clostridium difficile* and *Bacillus anthracis*, present unique challenges in medical treatment due to their remarkable resilience. Unlike typical bacteria, these organisms can form endospores—dormant, highly resistant structures that withstand extreme conditions, including heat, radiation, and antibiotics. This survival mechanism allows them to persist in environments where other pathogens would perish, making infections caused by these organisms particularly difficult to eradicate. For instance, *C. difficile* spores can survive on hospital surfaces for months, increasing the risk of healthcare-associated infections despite rigorous disinfection protocols.
One of the primary challenges in treating endospore-forming pathogens is their ability to evade standard antibiotic therapies. Endospores are metabolically inactive and lack the cellular targets that most antibiotics rely on to disrupt bacterial growth. As a result, conventional antibiotics like beta-lactams and aminoglycosides are often ineffective against these dormant forms. Even when the spores germinate into active bacteria, the treatment window is narrow, and the risk of recurrence remains high. For example, *C. difficile* infections frequently relapse, with up to 30% of patients experiencing a second episode within weeks of initial treatment. This necessitates prolonged or repeated antibiotic courses, which can disrupt the gut microbiome and exacerbate the problem.
Another complication arises from the limited treatment options available for these infections. While antibiotics like vancomycin and fidaxomicin are commonly used to treat *C. difficile*, their efficacy is not universal, and resistance is an emerging concern. For *B. anthracis*, the causative agent of anthrax, treatment requires a combination of antibiotics such as ciprofloxacin or doxycycline, often administered at high doses (e.g., 500 mg ciprofloxacin twice daily for adults) for extended durations (60 days). However, the success of treatment depends on early initiation, which can be challenging in cases of delayed diagnosis or bioterrorism exposure. Additionally, the use of antitoxins in conjunction with antibiotics highlights the complexity of managing these infections, as it requires careful coordination and specialized resources.
The persistence of endospores in the environment and within the host further complicates infection control. In healthcare settings, stringent disinfection measures, such as the use of spore-killing agents like chlorine bleach (5,000–10,000 ppm), are necessary to prevent transmission. However, these measures are not always feasible in all environments, leaving vulnerable populations at risk. For patients, the long-term shedding of spores in feces or other bodily fluids can lead to prolonged contagiousness, even after symptoms resolve. This underscores the need for innovative treatment strategies, such as spore-germination inhibitors or microbiome-restoring therapies like fecal microbiota transplantation (FMT), which has shown promise in reducing *C. difficile* recurrence rates by up to 90% in some studies.
In conclusion, the difficulty in treating infections caused by endospore-forming pathogens stems from their biological resilience, limited treatment options, and environmental persistence. Addressing these challenges requires a multifaceted approach, combining early diagnosis, targeted therapies, and rigorous infection control measures. As antibiotic resistance continues to rise, the development of novel treatments and preventive strategies will be critical to mitigating the threat posed by these dangerous pathogens.
Are Black Mold Spores Dangerous? Uncovering the Health Risks and Facts
You may want to see also

Environmental Persistence: How endospores remain dormant and spread in various environments
Endospores, the resilient survival structures of certain bacteria, can persist in environments for decades, even centuries, under conditions that would destroy most life forms. This remarkable durability stems from their multi-layered protective coat, low water content, and DNA-repair mechanisms. Unlike vegetative cells, endospores enter a dormant state, ceasing metabolic activity and becoming highly resistant to heat, radiation, desiccation, and chemicals. This dormancy allows them to withstand extreme environments, from the scorching deserts to the freezing tundra, and even the harsh conditions of outer space.
Consider the practical implications of this persistence. In healthcare settings, endospores of *Clostridium difficile* can survive on surfaces for months, posing a significant risk of infection, particularly to immunocompromised patients. Similarly, *Bacillus anthracis*, the causative agent of anthrax, can persist in soil for decades, making contaminated areas hazardous long after an initial outbreak. To mitigate these risks, stringent disinfection protocols are necessary. For instance, surfaces should be cleaned with sporicidal agents like hydrogen peroxide or chlorine-based disinfectants, and healthcare workers must adhere to strict hand hygiene practices.
The spread of endospores is equally concerning, as they can be dispersed through air, water, and soil. Wind-borne endospores of *Bacillus* species have been detected in dust storms, traveling vast distances and colonizing new environments. In aquatic systems, endospores can settle in sediment, remaining viable until conditions favor germination. This environmental mobility underscores the need for proactive monitoring and control measures. For example, water treatment facilities should employ filtration and disinfection processes capable of removing or inactivating endospores, such as reverse osmosis or ultraviolet (UV) irradiation.
Despite their dangers, understanding endospores’ environmental persistence offers opportunities for intervention. Researchers are exploring ways to exploit their dormancy mechanisms for biotechnology applications, such as preserving vaccines or enzymes in harsh conditions. Additionally, studying endospores’ resistance can inform the development of more effective sterilizing agents. For the general public, awareness of endospores’ persistence highlights the importance of proper food handling and environmental hygiene. Simple measures, like boiling water in areas with known contamination or using HEPA filters to reduce airborne spores, can significantly reduce exposure risks.
In conclusion, the environmental persistence of endospores is a double-edged sword, presenting both challenges and opportunities. Their ability to remain dormant and spread widely necessitates vigilant control measures, particularly in healthcare and water treatment settings. Yet, by understanding their unique biology, we can develop innovative solutions to combat their pathogenic potential and harness their resilience for beneficial purposes.
Mastering Fern Propagation: A Step-by-Step Guide to Growing from Spores
You may want to see also
Frequently asked questions
No, not all endospore-forming organisms are dangerous pathogens. While some, like *Clostridium botulinum* and *Bacillus anthracis*, can cause severe diseases, many others are harmless or even beneficial, such as those used in probiotics or soil ecosystems.
Endospore-forming organisms are considered potential threats because their endospores are highly resistant to extreme conditions, including heat, radiation, and chemicals. This resistance allows them to survive in harsh environments and contaminate food, medical equipment, or other materials, potentially causing infections or outbreaks.
While endospore-forming pathogens can be challenging to eradicate due to their resilience, they can often be treated with specific antibiotics or controlled through sterilization methods like autoclaving. However, their ability to form spores requires more aggressive measures compared to non-spore-forming bacteria.












